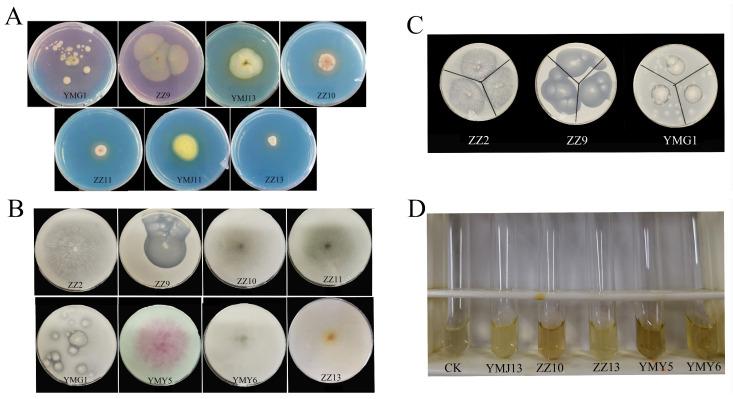
https://cdn.ncbi.nlm.nih.gov/pmc/blobs/8ec6/11508408/02e2f9ccc072/jof-10-00713-g003.jpg

探索从霍尔特分离的内生真菌促进植物生长的特性及其在植物生长发育中的相互作用。
Exploring Plant Growth-Promoting Traits of Endophytic Fungi Isolated from Hort and Their Interaction in Plant Growth and Development.
作者信息
Wang Qing, Zhang Xinyu, Xie Qiqi, Tao Jiwen, Jia Yujie, Xiao Yirong, Tang Zizhong, Li Qingfeng, Yuan Ming, Bu Tongliang
机构信息
College of Life Sciences, Sichuan Agricultural University, Ya'an 625014, China.
Sichuan Agricultural University Hospital, Ya'an 625014, China.
出版信息
J Fungi (Basel). 2024 Oct 12;10(10):713. doi: 10.3390/jof10100713.
Endophytic fungi inhabit various plant tissues and organs without inducing evident disease symptoms. They can contribute positively to the growth of plants, bolster plants resilience to environmental and biological stresses, and facilitate the accumulation of secondary metabolites. These microbial resources possess significant developmental and utilization value in various applications. Hence, this study focused on exploring the plant growth-promoting (PGP) traits of 14 endophytic fungi from Hort (CX) and elucidating the effects and mechanisms that facilitate plant growth. According to PGP activity evaluation, the majority of strains demonstrated the capacity to produce IAA (78.57%), siderophores (50.00%), ammonia (35.71%), potassium solubilization (21.43%), nitrogen fixation (57.14%), and phosphate solubilization (42.86%). Further investigations indicated that the levels of IAA ranged from 13.05 to 301.43 μg/mL, whereas the soluble phosphorus levels ranged from 47.32 to 125.95 μg/mL. In cocultivation assays, it was indicated that sp. YMY5, sp. YMY6, sp. ZZ10 and sp. ZZ13 had a certain promoting effect on lateral root number and fresh weight of tobacco. Furthermore, ZZ10 and ZZ13 significantly enhanced the germination potential, germination index, and vigor index of tobacco seeds. The subsequent potted trials demonstrated that the four endophytic fungi exhibited an enhancement to growth parameters of tobacco to a certain extent. ZZ10 and ZZ13 treatment had the best promotion effect. Inoculation with YMY5 increased the chlorophyll a and total chlorophyll content. ZZ10 and ZZ13 treatment remarkably increased the net photosynthetic rate, soluble sugars and soluble protein content, catalase and peroxidase activities, and lowered malondialdehyde content in tobacco leaves. In addition, YMY5 remarkably elevated superoxide dismutase activities. ZZ13 upregulated the expression of growth-related gene. Among them, ZZ13 had a better growth-promoting effect. In conclusion, these endophytic fungi possessing multi-trait characteristics and the capacity to enhance plant growth exhibit promising potential as biofertilizers or plant growth regulators.
内生真菌栖息于各种植物组织和器官中,却不引发明显的病害症状。它们能对植物生长产生积极作用,增强植物对环境和生物胁迫的抵御能力,并促进次生代谢产物的积累。这些微生物资源在诸多应用中具有重要的开发和利用价值。因此,本研究着重探索来自霍尔特(CX)的14种内生真菌的促植物生长(PGP)特性,并阐明其促进植物生长的效果和机制。根据PGP活性评估,大多数菌株表现出产生吲哚乙酸(IAA)的能力(78.57%)、铁载体(50.00%)、氨(35.71%)、解钾能力(21.43%)、固氮能力(57.14%)和解磷能力(42.86%)。进一步研究表明,IAA水平在13.05至301.43μg/mL之间,而可溶性磷水平在47.32至125.95μg/mL之间。在共培养试验中,结果表明YMY5菌、YMY6菌、ZZ10菌和ZZ13菌对烟草的侧根数和鲜重有一定的促进作用。此外,ZZ10菌和ZZ13菌显著提高了烟草种子的发芽势、发芽指数和活力指数。随后的盆栽试验表明,这四种内生真菌在一定程度上对烟草的生长参数有增强作用。ZZ10菌和ZZ13菌处理的促进效果最佳。接种YMY5菌增加了叶绿素a和总叶绿素含量。ZZ10菌和ZZ13菌处理显著提高了烟草叶片的净光合速率、可溶性糖和可溶性蛋白含量、过氧化氢酶和过氧化物酶活性,并降低了丙二醛含量。此外,YMY5菌显著提高了超氧化物歧化酶活性。ZZ13菌上调了生长相关基因的表达。其中,ZZ13菌具有更好的促生长效果。总之,这些具有多种特性且能促进植物生长的内生真菌作为生物肥料或植物生长调节剂具有广阔的应用前景。